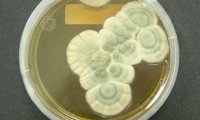
90-летняя плесень ушла с молотка за 15 тысяч долларов

Одинокого японца задавило насмерть шестью тоннами порножурналов
Японец, который жил в одиночестве и не имел постоянного партнера, ушел из жизни после того, как на него обрушилось шесть тонн порножурналов. Об этом сообщает Daily Mail.

Японец, который жил в одиночестве и не имел постоянного партнера, ушел из жизни после того, как на него обрушилось шесть тонн порножурналов. Об этом сообщает Daily Mail.

Датские специалисты признали морскую капусту наиболее подходящей пищей для людей, которые столкнулись с заболеваниями сердца и сосудов. Кроме того, они посоветовали употреблять морскую капусту для...

Американская модель Джиджи Хадид приняла участие в съемке для обложки арабской версии журнала Vogue. Кадры с фотосессии опубликованы на страничке издания в Instagram.
Бывший гендиректор «Аэрофлота» Валерий Окулов, который последние восемь лет занимает пост замглавы Минтранса, может покинуть министерство, узнало RNS. По информации источников агентства, это может...
С соответствующим распоряжением пообещал выступить глава украинского Минэнерго Игорь Насалик. В министерстве опасаются, что Москва будет перепродавать Киеву уголь из Донбасса.

Известно, что в бассейнах содержится определенное количество мочи. Смешиваясь с хлорированной водой, моча может образовывать токсичное для легких человека сочетание.

Супруги из британского города Оксфорд, у которых нет возможности иметь собственных детей, начали присматривать за игрушечными младенцами. Об этом пишет Metro.
Минфин, в прошлом месяце вышедший на внутренний рынок валюты, вынужден сократить объемы закупок, поскольку доходы от продажи нефти оказались меньше, чем ожидалось.

С провокацией взятки со стороны одной из этнических групп Москвы пришлось столкнуться работникам национального парка "Лосиный остров". Коллектив нацпарка обратился к ген. прокурору Юрию Чайке с...
Глава украинского Минэнерго сообщил, что внесет в кабинет министров распоряжение о запрете на импорт антрацитового угля из России. По его словам, Москва может перепродавать Киеву уголь из Донбасса,...

Специалисты из Института биоорганической химии и нескольких других исследовательских центров выяснили, как образовываются пятна на шкуре у зародыша животных.

Специалисты впервые восстановили мягкие ткани древнейших предков птиц, что позволило выяснить, что динозаврам 160 миллионов лет назад было под силу совершать полеты. Об этом говорится в статье,...

Новый анализ черепов из восточной Бразилии указывает на то, что типичные индейцы появились в Америке позже, чем австралоиды. Авторы не делают предположений относительно маршрутов, по которым...

В современном мире люди все чаще используют интернет для заказа еды домой. Такие покупки экономят силы и время. Однако они, по мнению экспертов, очень вредны в долгосрочной перспективе.
Аукционному дому Bonhams (Великобритания) удалось продать 90-летний экземпляр застаревшей плесени из лабораторного кабинета бактериолога Александра Флеминга.

Достичь такого прорыва в этом направлении российским специалистам удалось благодаря успешному синтезу белка «теплового шока», который обеспечивает клеткам организма защиту от повреждений

Глава Новосибирской области Владимир Городецкий своим распоряжением ввел ответственность для подчиненных за срыв или несвоевременное исполнение указов президента и правительства РФ, а равно и своих...

Обязательный ремонт вместо денежной выплаты позволяет страховым компаниям умерить аппетиты участников ДТП, недовольных выплатами: часто юристы доказывают ущерб, который подрывает рентабельность...

После этих манипуляций своеобразная заготовка была на четверо суток помещена в емкость с питательным раствором, чтобы воссоздать идентичные внутриутробным условия.

Электронные деньги более просты в управлении, на них не нужно тратить сырье, а их транспортировка не стоит ничего, а качество не изменяется. Самое важное преимущество электронных денег – их удобство...